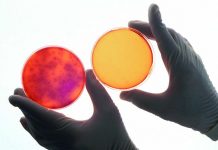
The declining trend of salmonellosis cases in the EU has levelled off

Managing feed withdrawal with food safety and carcass yield in mind
The feed withdrawal program aims at minimizing the occurrence of fecal contamination at plant, thus shielding the products’ safety. It happens that while off...
Pre-harvest interventions and implications of safety for turkey processing
Increasing consumer attention toward low fat, high protein diets, and demand for healthy foods has led to a significant increase in the production and...
Performance, immunity and blood biochemical parameters of broiler chickens fed diets containing Kappaphycus alvarezii
Kappaphycus alvarezii (KPA) can be incorporated at 1.50% in diets for improved performance, immuno-responsiveness and blood biochemical parameters in broiler chickens.
Introduction
Kappaphycus alvarezii (KPA) is...
The benefits of nipple drinker catch trays
USPOULTRY and the USPOULTRY Foundation announced the completion of a funded research project at the University of Georgia in Athens, Georgia, in which researchers...
Metabolic differences in the blood of chick embryos
A study was conducted in order to investigate metabolic differences in the blood of chick embryos and post-hatch chicks from two egg sizes and...
Pirbright research to boost vaccine production
Scientists at the Pirbright Institute have received money, which will enable research into boosting vaccine yields by up to ten fold. The funding was...
Is no antibiotics ever (NAE) poultry production sustainable?
For many years, commercial poultry feeds in the United States contained sub-therapeutic levels of antibiotics, commonly known as antibiotic growth promoters (AGPs), to maximize...
Novel genome technologies to ensure future biodiversity and global protein request
A new collaborative research and development project between Cobb-Vantress and The Roslin Institute brought scientists and industry experts together to address food security needs...
Gaining a better understanding of incubation in a hatchery
The contemporary hatchery is a complex installation. The core part is the incubators, supported by the devices that facilitate their function and auxiliary machines...
Evaluation of anti-inflammatory capacities of bacillus-based probiotics using an in vitro intestinal cell model
With the evolution of genetic potential of modern broilers, transforming the large feed intake into protein deposition is a real challenge for the digestive...
Management best practices: small details can have the big-gest impact
Raising turkeys is equal parts science and art. It involves precise measurement of various factors throughout the life of the flock. It also requires...
Re-programming of broiler growth and immunity through changes in breeder hen bodyweight
Reprogramming of broiler growth and developmental events is increasingly recognised as having lifelong effects on animal health, welfare and productivity. Whilst most studies have...
Detection of antibodies against Chlamydia species in chicken serum
Avian chlamydiosis is a bacterial infection caused by Chlamydia bacteria. The currently available tests distinguish Chlamydia species based on genetic material. Researchers from Wageningen...
Effects of yeast and its derivatives on meat yield
The present experiment was designed to determine the effects of yeast and its derivatives on meat yield and hematological indices of broiler chickens challenged...
Origin of feed ingredients in Dutch compound feeds
Wageningen University and Research (WUR) studied the origin of protein-rich feed ingredients, which in 2018 were applied in Dutch compound feeds. 65% of proteins...
Turkey dermatitis/cellulitis: where are we headed?
Clostridium septicum is a ubiquitous, spore-forming bacterium associated with spontaneous gas gangrene in both livestock and humans. The spores can persist in harsh environments,...
Understanding and managing water for successful flocks
Water is the single greatest input into the production of poultry products such as eggs and meat. The fact water is a relatively inexpensive...
Microbiological consequences of different housing systems for laying hens, with particular reference to Salmonella...
A significant proportion of human illnesses caused by Salmonella are linked to the consumption of contaminated eggs. In response, substantial government and private industry...
Egg deposition of maternal testosterone is controlled by the pre-ovulatory peak of luteinizing hormone
Variability of androgen concentrations in the avian egg is often explained by an adaptive hypothesis according to which differential maternal deposition of yolk hormones...
A diagnostic laboratory perspective for pathogen detection
Detection of infectious diseases can generally be broken down into laboratory detection of the pathogen or detection of the immune response to the pathogen....
Solar energy ensures cost-efficiency
Solar energy radiation means revenues – at least for farmers who have successfully harnessed renewable energies. However, with the latest amendment to the Renewable...
A novel microbiome metabolic modulator improved growth performance and intestinal morphology during a coccidiosis...
The present study was designed to investigate the effects of a precision glycan Microbiome Metabolic Modulator (MMM) on growth performance and gut health parameters...
Management of ectoparasites in cage-free housing systems
As cage-free systems become more frequent in poultry production, we are forced to evaluate how pest control measures should adapt to ensure efficacy.
The...
Partially slotted flooring systems for market toms – What are the possibilities?
Avian influenza virus is stable longer in moist and cool conditions. Depending on seasonal and production conditions barn air and litter (bedding) moisture can...
Sample management and handling for diagnostic testing
Diagnostic testing is an important and widely used tool in commercial poultry husbandry. A key to best use of diagnostic testing, is to begin...
Chicken study probes resistance to food bug
Receiving gut microbes from resistant chickens does not lessen chickens’ susceptibility to bacterium that causes food poisoning.
Susceptible chickens became even more susceptible to Campylobacter,...
Peak food and our quest for an ethical and ecologically sustainable production
Crude analyses of sustainable global resource use suggest that the peak rate year for commercial poultry production was reached in 2006 while projections indicate...
Rapid in vitro antimicrobial screening assay against Campylobacter
Research was undertaken to adapt a multi-well antimicrobial assay as a fast and reliable method to screen large numbers of plant extract treatments against...
A multidisciplinary research approach on Avian Influenza in Italy
The Avian Influenza epidemic of 2016-2017 had been the largest in Europe in more than 10 years. The circulating virus was a Highly Pathogenic...
Enumeration of Ascaridia Galli eggs in chicken excreta
Excreta counting techniques in eggs can provide valuable information for assessing flock infection levels, selecting nematode resistant chicken breeds and for determining anthelmintic efficacy.
Although...
Brooding
Getting chicks off to a good start is very important to overall flock performance. At no time does a bird grow faster than during...
Determining the correct temperature for transporting 18-day incubated eggs
On-farm hatching is now fairly common in some countries, it requires incubated eggs to be transported from the hatchery to the farm at 18–18.5...
Comparative sustainability of differing dietary amino acids and energy regimes for individual laying hens...
Poultry production has been identified as an efficient source of terrestrial, farmed animal protein. However, in tandem with all food production, sustainability into the...
Get the most from your diagnostic laboratory.
A field perspective.
You notice the
mortality is up this morning in one of your brooder houses. Your first thought
might be “better take some birds to...
Flip-overs: causes and solutions in brooding
The poult start is an extension of the hatching process. The whole process, including poult placement, is only as strong as its weakest link.
William...
Lasers prevent the spreading of the Avian Influenza virus
Wageningen University released their research on a poultry farm that suffered visits from wild waterfowl, which are a source of Avian Influenza virus. The...
Detection and quantification of Gallibacterium anatis and Mycoplasma synoviae
Mycoplasma synoviae is one of the most common preconditions for secondary bacterial infections in poultry. It causes subclinical infections of the upper respiratory tract,...
The role of early experience on the behavior of hens housed in cage-free aviaries
Understanding the consequences of rearing experiences on the behavior and bone integrity of laying hens can help inform solutions to animal welfare and management...
Managing eggs and chicks from young breeders
First week mortality is often higher in chicks from very young breeders (25-30 weeks) than in chicks from older breeders. What causes these chicks...
Estimated total cereal production in the EU-27 for the 2022 harvest
Experts from the Copa and Cogeca working groups on cereal and oilseed gathered in Brussels, with an estimated total cereal production of 277 million...
Cost-effective biosecurity management practices
An effective flock health plan must integrate solid strategies for disease prevention, rapid diagnosis, and effective treatment to support poultry health. To attain this...
Diagnostic strategies for the control of avian Mycoplasmas
Mycoplasmas are bacteria without the cell wall which cause infections in poultry especially at respiratory and articular level.
They are the smallest single-celled organisms found...
Dietary xylanase improves growth performance and cost savings in broiler chickens fed a corn-soybean...
The increased demand to reduce production costs, as well as concerns about the environment, have resulted in pressure on poultry producers to increase dietary...
Protein digestive dynamics influence growth performance of broiler chickens
Three apical diets were formulated to stimulate different protein digestion rates dependent on the major constituents: standard (soybean meal), rapid (whey protein) and very...
Spent hens: Can we improve their welfare?
The aim of this study was to observe the improvement in welfare indicators of spent hens kept in three different housing systems.
Sixteen Isa...
Barley in pelleted broiler starter diets: effects of carbohydrase supplementation and steam-conditioning temperature
The effect of pelleting barley-based diets on bird performance and nutrient utilisation depends, in part, on the conditioning temperature (CT) used. The influence of...
A new view of how class I molecules fight diseases
Classical class I molecules of the major histocompatibility complex (MHC) play crucial roles in defence against viruses.
The class I molecules bind pieces of protein...
Researchers investigate the characteristics of Turkey Hepatitis Reovirus
USPOULTRY and the USPOULTRY Foundation announced the completion of a funded research project at the University of Minnesota in which researchers investigated the characteristics of Turkey...
Improving feeding efficiency with innovating products
At Trouw Nutrition they have focused their innovation in the poultry business on finding new ways of achieving improved feeding efficiency and enhanced performance...
VAL-CO, clean and dry feed from delivery to consumption
A VAL-CO feed storage and transport system is designed to keep feed clean and dry from delivery to consumption. Store your feed in our...
Understanding resistance to different Infectious Bronchitis virus genotypes
In previous experiments, we have challenged major histocompatibility complex (MHC) congenic chicken lines available at UC Davis with an infectious bronchitis virus (IBV) M41...
Breast meat quality affected by wooden myopathy
Wooden breast (WB) is a myopathy that affects meat quality traits in modern broilers and it has been associated with an increased BW gain...
NRGene to offer the first broad soy diversity & haplotype database
All-by-all full genome comparison of 30+ varieties to rapidly improve nutrition and hardiness and reduce resource requirements
NRGene, the leading genomic big data company, has...
Use of commercial premixes with low levels of organic trace minerals on egg production...
Common industry practice is to supply trace minerals well above published recommendations. An experiment was conducted to examine the effects of two commercial premixes...
How a single Avian Influenza protein can increase period of infection
New research led by scientists at The Pirbright Institute has shown how an Avian Infuenza a virus protein, called PB1-F2, is able to shut...
A Box-Behnken assessment of fishmeal and sorghum inclusions in broiler diets
The objective of this study was to investigate the impacts of starch and protein digestive dynamics on broiler growth performance using Box-Behnken response surface...
Engineering vaccines for multiple strains of IBV
In new work funded by a Biotechnology and Biological Sciences Research Council (BBSRC) researchers at The Pirbright Institute and The Roslin Institute have published...
Does the external climate matter?
The optimum climate parameters for embryo development – temperature, humidity, and the balance between oxygen supply and carbon dioxide release from the incubator –...
Integrated Microfluidic Device for rapid Avian Influenza virus capture
Rapid detection of avian influenza virus (AIV) is highly desirable during outbreaks or routine AIV surveillance.
In this project, the preliminary results in developing a...
Research shows how Infectious Laryngotracheitis can spread from vaccinated flocks
The research on how Infectious Laryngotracheitis can spread from vaccinated flocks was made possible in part by an endowing Foundation gift from Claxton Poultry...
Transgenerational impact of broiler breeder nutrition
Continuous genetic selection in meat-type chicken for rapid growth resulted in increased meat production and decreased the time required for achieving the market weight....
In Observance of Earth Day USPOULTRY highlights poultry and egg farm and poultry facilities...
In observance of Earth Day, celebrated on April 22, U.S. Poultry & Egg Association highlighted two videos from its series emphasizing environmental stewardship on...
Researchers investigate how laying hens visually perceive the resources in cage-free housing
USPOULTRY and the USPOULTRY Foundation announced the completion of a funded research project at Purdue University in which researchers investigated how laying hens visually...
Comparison of four injection sites for Se bacterin vaccine in commercial pullets
As commercial pullets farming transitions from rearing a bird on a single level in conventional-style housing to rearing a bird in a multi-level aviary,...
Getting to the bottom of sex-related first week mortality in the hatchery
"Why are so many chicks dying in their first week in the hatchery?" I could hear the worry in his voice when I received...
Energy utilization in broilers fed a sorghum-based diets supplemented with phytase and carbohydrases
This study was conducted to evaluate the endogenous enzyme activities and energy utilization of broilers fed sorghum-based diets supplemented with phytase and carbohydrases
Broilers were...
Researchers characterize selected variant Avian Reovirus strains
USPOULTRY and the USPOULTRY Foundation announce the completion of a funded research project at the University of California, Davis, in which researchers looked to...
Methionine supplementation reduces plasma amino acid circulation and enhanced apparent digestibility in broiler chickens
The objective of this study was to evaluate the impact of methionine supplementation on amino acid concentration in systemic plasma, apparent amino acid digestibilities...
Transparency, communication and engagement with society
Transparency, communication and engagement are the Aviagen’s powerful tools to achieve supply chain and industry success.
Late US President Dwight D. Eisenhower once said,...
Protozoal management in turkeys
The two turkey protozoa that cause significant animal welfare and economic distress include various Eimeria species of coccidia and Histomonas meleagridis. For coccidia, oral...
Influence of age on the standardised ileal amino acid digestibility of maize and barley...
Grains are the major energy sources in broilers. However, they also supply about 40% of the total dietary protein and contribute significantly to the...
Animal breeding reduces environmental impacts
Results of a study show that breeding reduces environmental impacts of animal products by about 1% per year. This is achieved without specific selection...
The use of antibiotics in the poultry industry
Antimicrobial resistance in human and animal isolates in the E.U. remains a significant problem despite the bans of antibiotic growth promoters and the reductions...
Roxell launches Siroc Sterling™ space heater for tall poultry houses
Roxell, the leading manufacturer of automated feeding, drinking, nesting and heating systems, is expanding its range of convection heaters for poultry houses with the...
A new research shows persistent Salmonella strains on processing equipment
The USPOULTRY Foundation announce the completion of a funded research project at Clemson University in Clemson, S.C., in which Dr. Kay Cooksey and other...
Improving poultry products safety
The research is part of the Association’s comprehensive research program encompassing all phases of poultry and egg production and processing.
Dr. Hong Zhuang at...
Boosting the cell-mediated immunity in chickens post-hatch via pre-hatch delivery of nucleic acids
Respiratory virus infections such as Avian Influenza, infectious laryngotracheitis and infectious bronchitis lead to high morbidity and mortality in chickens globally.
Given the limitations...
Reaching full potential with Innova IMPAQT
A real-time impact on performance, availability and quality
A modern poultry processing plant is a complex network of interconnecting processes operating at high speed. It...
The role of mechanistic theory in delaying the development of NSPases
This brief paper attempts to review the history of development of the mechanistic theories for NSPases and how this has possibly delayed advances.
NSPase feed...
The declining trend of salmonellosis cases in the EU has levelled off
Cases of Salmonella Enteritidis acquired in the EU have increased in humans by 3% since 2014 says the report, which is compiled by the...